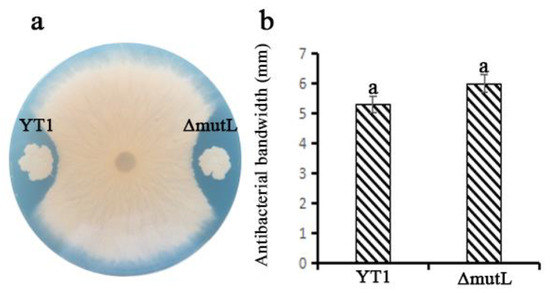

Abstract
The purpose of this study is to discover and excavate more key factors and signaling pathways that regulate the formation intensity of biofilms and to fully reveal the possible models affecting biofilm formation. By using gene homologous recombination and bioinformatics technology, a MutL protein-directed deletion mutant strain was successfully constructed. The growth status of the mutant strain was observed, and it was confirmed that, except for the change in cell morphology, there were no significant differences in growth and reproduction between the mutant strain and the wild-type strain. By using the induced biofilm formation technique, the significant decrease in biofilm formation in the MutL mutant strain was successfully verified. The plate confrontation test confirmed that the inhibitory ability of the mutant strain against rice blast fungus was not significantly different from that of the WT strain. The colonization ability of the mutant strain on rice stems was tested, and it was confirmed that the colonization ability of the mutant strain was significantly lower than that of the WT strain. In terms of the prevention and control effect of rice blast disease, the mutant strain showed a significant decrease. By using transcriptomic big data, the gene and pathway expression differences between the mutant strain and the WT strain during biofilm formation were analyzed. The analysis revealed no significant correlation with the previously reported spo0A and tapA-sipW-tasA pathways. The key factor capB of the polyglutamic acid signaling pathway, which affects the formation of the biological model, was found to have a significant decrease in expression. A mechanical hypothesis was proposed: MutL may participate in regulating the formation intensity of Bacillus biofilms by regulating the formation of glutamic acid to polyglutamic acid.
1. Introduction
Bacillus have the ability to form intricate and cell-aggregated communities called biofilms [1]. The presence of biofilm morphology enables Bacillus to effectively resist pathogen infections [2,3]. Additionally, successful biofilm formation enhances the colonization of Bacillus on plant surfaces [4]. For example, PGPR PaeniBacillus polymyxa can colonize the root tips of Arabidopsis thaliana, enhancing the biocontrol effect against pathogens [5]. In B. subtilis 6051, biofilm formation, colonization, and surfactin secretion collectively contribute to biocontrol effects against Pseudomonas syringae [6].
Bacterial biofilms can form on both biological and non-biological surfaces and typically progress through five steps: plankton, attachment, microcolony formation, macrocolony formation, and biofilm dispersion [7,8,9]. Once bacteria adhere to a surface, they will immediately begin to aggregate to form microcolonies. At this stage, there are significant changes in gene expression within the cells, such as the suppression of genes related to motility and the enhancement of genes involved in extracellular matrix synthesis. Microcolonies further expand and mature to form stable, complex biofilm structures [10,11]. Biofilms are composed of extracellular matrix materials such as extracellular polysaccharides, proteins, nucleic acids, and lipids, as well as the micro-organisms embedded within them [12,13,14]. In Bacillus, the extracellular matrix of biofilms primarily refers to the extracellular polysaccharides synthesized by the epsA-O operon (epsABCDEFGHIJKLMNO) [15,16], the amyloid protein TasA and hydrophobic protein BslA (encoded by bslA) synthesized by the operon tapA-sipW-tasA [17,18], extracellular DNA (eDNA) [19], polyglutamic acid [20], and mineral scaffolds [21].
Biofilms consist of multiple subpopulations of cells with the same genotype but differentiated phenotypes [22]. These subpopulations are capable of specifically producing or responding to different signals and are responsible for various functions within the biofilm. This process is primarily regulated by three regulatory factors, DegU, ComA, and Spo0A [23,24], which control gene expression by altering their own phosphorylated states. When all three factors are in their non-phosphorylated states, genes related to cell motility are expressed at high levels, and the cell subpopulation is primarily motile [25]. When cells are in an attached state, these regulatory factors respond to intracellular and extracellular signals, activating the expression of genes involved in extracellular matrix synthesis and inhibiting the expression of motility genes [26]. This also means that the motile cell subpopulation exists independently of other subpopulations, while the differentiation of other cell subpopulations may overlap [27]. The ComA regulatory factor primarily activates the differentiation of cells into competent cell subpopulations. Phosphorylated ComA (ComA-P) activates the expression of surfactin, which in turn stimulates the synthesis of extracellular matrix by cells [9,28]. The activated form of DegU (phosphorylated DegU, DegU-P) can stimulate the differentiation of cells into subpopulations capable of producing extracellular proteases [29]. These proteases can degrade larger extracellular molecules into smaller ones that can be recycled by the cells. The cell subpopulation may preferentially differentiate into motile cells or extracellular matrix-producing subpopulations. Furthermore, DegU-P can also positively regulate the expression of BslA protein [30].
The study successfully constructed a mutant strain of Bacillus amyloliquefaciens YT1 with a mutation in the mutL gene. It was verified that the mutant strain had a significant defect in biofilm formation. It was observed that the mutant strain had a significantly reduced colonization ability on the stems inoculated with the rice blast fungus and a significant decrease in the prevention and control ability of rice blast. The expression level of the key node gene capB in the polyglutamic acid signaling pathway was significantly decreased [31]. A mechanical hypothesis was proposed: MutL significantly positively regulates the formation strength of biofilms by controlling the signaling pathway of glutamic acid polymerization to form polyglutamic acid.
2. Materials and Methods
2.1. Strains and Culture Conditions
The specifics of the strains and plasmids employed in this study are detailed in Table 1. The WT B. amyloliquefaciens YT1 and the MutL mutant were cultured in Luria-Bertani (LB) broth medium, which consisted of 10 g/L tryptone, 5 g/L yeast extract, and 10 g/L NaCl. The samples were kept in an incubator set at 37 °C and were subjected to orbital shaking at 200 rpm. Escherichia coli DH5α was cultured in LB broth medium and used for vector preparation to disrupt the mutL gene in WT B. amyloliquefaciens YT1. Rhizoctonia solani was propagated on potato dextrose agar (PDA) medium at 28 °C [32].

Table 1.
List of bacterial strains and plasmids employed in the research.
To conduct biofilm formation assays, both B. amyloliquefaciens YT1 and its MutL mutant were cultivated in MSgg medium [33,34], which is a formulation containing 5 mM potassium phosphate (pH 7), 100 mM Mops (pH 7), 2 mM MgCl2, 700 µM CaCl2, 50 µM MnCl2, 50 µM FeCl3, 1 µM ZnCl2, 2 µM thiamine, 0.5% glycerol, 0.5% glutamate, 50 µg/mL tryptophan, and 50 µg/mL phenylalanine, where antibiotics were incorporated as required at the following concentrations: 100 µg/mL ampicillin, 100 µg/mL spectinomycin, 20 µg/mL neomycin, and 5 µg/mL chloramphenicol, based on previous studies [35].
2.2. The Establishment of WT B. amyloliquefaciens YT1 Mutant Libraries and the Isolation of the mutL Gene
We generated a random mutant library of B. amyloliquefaciens YT1 using the plasmid pMarA, which harbors the transposon TnYLB-1, thus illustrating effective random insertion into chromosomal sites [36]. Several single colonies from this mutant library were inoculated into 4 mL of LB medium with spectinomycin for the mutants and incubated at 37 °C with shaking for 12 h. In addition to the mutant library, a control strain of B. amyloliquefaciens YT1 derived from a single colony was cultured under the same conditions but without the addition of spectinomycin. Next, 200 µL of each culture was inoculated into 4 mL of MSgg medium and incubated statically at 37 °C for 24 h. By visually inspecting the biofilm formation, we were able to observe any significant changes in the mutants compared to the WT strain B. amyloliquefaciens YT1. Each experiment was replicated three times. After screening thousands of mutants, we identified the MutL mutant as having significant deficiencies, and we confirmed that it had only one insertion site through Southern Blot analysis.
2.3. Construction of the ΔmutL Mutant and Tagging Strains with GFP
To obtain a spectinomycin resistance gene and its promoter, we used the primers SpecF (5′-TTTGGATCCCTGCAGCCCTGGCGAATG-3′) and SpecR (5′-TTTGAATTCAGATCCCCCTATGCAAGG-3′) (BamHI and EcoRI restriction sites are underlined) from plasmid pDG1728. The complete spectinomycin cassette, digested with the BamHI and EcoRI restriction enzymes, was cloned into the plasmid pUC19, resulting in the construction of pUCSpec. We then obtained a PCR product of mutL (741 bp) from the genomic DNA of the WT B. amyloliquefaciens YT1 using the primers MutLF (5′-TTTAAGCTTATTTACGGGACGGCGGTTGC-3′) and MutLR (5′-TTTGGATCCGCTGGGCGCTCGGAATAAGC-3′) (HindIII and BamHI restriction sites are underlined). The plasmid pUCSpec-MutL was created by inserting this digestion product into pUCSpec. The ΔmutL mutant was generated by transforming the pUCSpec-MutL plasmid into B. amyloliquefaciens YT1 through the process of genetic transformation. Additionally, we successfully constructed the positive emission green fluorescent protein (GFP) strains ΔYT1-gfp and ΔmutL-gfp by transforming the plasmid pRp22-gfp into the WT B. amyloliquefaciens YT1 and the ΔmutL mutant, respectively.
2.4. Antifungal Activity of YT1 and ΔmutL Mutant against R. solani
R. solani mycelial plugs, each with a diameter of 7 mm, were grown on PDA medium for three days and subsequently transferred to the center of LB plates. Two microliters of YT1 strain and the ser mutant culture were carefully placed onto a 6 mm circular filter paper disk and uniformly distributed around the mycelial plugs. Following the addition of the culture to the filter paper disks, the plates were securely covered with parafilm and placed in an incubator set at 28 °C. The diameter of the inhibition zone (antibiosis zone), indicating the inhibitory effect of the B. amyloliquefaciens on R. solani mycelial growth, was measured after 24 to 72 h of incubation.
2.5. Colonization Detection in Rice Plants Using Confocal Microscopy and Assessment of Biocontrol Efficacy against Rice Sheath Blight
The R. solani bacterial cakes, with a diameter of 6 mm, were cultured for 3 days in solid PDA medium. These cakes were then inoculated into 100 mL of liquid PDA medium with 200 matchsticks without Commelina. The cakes were incubated in a 500 mL flask without shaking at 28 °C for one week. Thirty seeds of a rice cultivar were soaked in water for 24 h and then sown in a nursery containing sterile organic soil. Five days before the heading stage of rice, ten matchsticks infested with R. solani were inserted into the 2–3 cm region of each rice leaf. Approximately 20 mL of broth, cultured for 48 h, from the WT B. amyloliquefaciens YT1-gfp and ΔmutL-gfp mutant strains were evenly sprayed onto the rice plants marked by the matchsticks. From 0 to 12 d after the initial inoculation, the rice leaves marked by the matchsticks were observed and captured using a confocal microscope equipped with a 40× objective lens (Carl Zeiss LSM710, Oberkochen, Germany). Lesion length of strains was measured as the primary criterion for assessing the biocontrol effects against rice sheath blight. Each treatment group consisted of eight individual pots.
2.6. Genomic Transcript Levels Analyzed between WT B. amyloliquefaciens YT1 and the ΔmutL Mutant Using the Illumina HiSeqTM2500 Platform
Total biofilm RNA from both the WT B. amyloliquefaciens YT1 and the ΔmutL mutant, cultured in a static MSgg medium (4 mL in 12-well microtiter plates) at 37 °C for 24 h, was extracted using an RNAprep pure Cell/Bacteria Kit. The extracted RNA was qualified using the 2100 Bioanalyzer test. A total of 10 µg RNA was treated with 5U DNaseI (Takara, Osaka, Japan) for 30 min at 37 °C, followed by purification using an RNeasy MinElute Cleanup Kit (Qiagen, Beijing, China). Ribo-Zero™ Magnetic Kit (TransGen, Beijing, China)was utilized to eliminate all rRNA by conducting a reaction at 68 °C for 10 min and room temperature for 5 min. Subsequently, a cDNA library was constructed using the NEB Next® UltraTM Directional RNA Library Prep Kit for Illumina (NEB, Ipswich, MA, USA), followed by cluster generation and sequencing on an Illumina HiseqTM2500 platform. Linker sequences containing low-quality clean reads were removed using fastx_clipper. Unwanted, low-quality reads (>20 bases) from 3′ to 5′ ends were eliminated using a FASTQ Quality filter (FASTX-Toolkit, v0.0.13). Reads less than 50 bp in length were excluded as clean reads. Quality assessment of the sequencing data was performed with Fastqc software (v0.10.0). Differential gene expression analysis was conducted by mapping clean reads to the reference genome using Bowtie 2 (version 2.1.0) and employing an MA-plot-based method with a random sampling model. Gene expression levels in both the WT YT1 and ΔmutL mutant strains were determined. Genes showing significant differential expression with fold change >2, FDR(q value) < 0.001, and at least one sample with an RPKM (Reads Per Kilobase Million) value greater than 20 were selected for further analysis.
3. Results
3.1. The Acquisition of the mutL Gene
Through biofilm phenotype testing and bioinformatic analysis of a random insertion mutant library of WT B. amyloliquefaciens YT1, the mutL gene, which is associated with decreased biofilm phenotype, was identified. By employing homologous recombination, a single-gene knockout mutant with a MutL deficiency was successfully generated and characterized.
This MutL mutant showed a significant reduction in biofilm formation, and its structure was barely visible, with only subtle projections distinguishing it from the well-defined three-dimensional architecture and intricate patterns of YT1 (Figure 1). Analysis of the biofilm network width (NW) for the MutL mutant revealed that its density was merely one-tenth that of the WT. In terms of colony morphology, the MutL mutant lacked a continuous edge and clear projections, presenting an incomplete and planar structure in contrast to the robust three-dimensional growth of WT YT1 (Figure 2). However, the mutant strain can grow and reproduce normally without significant differences compared to the YT1 strain (Figure 2). These findings indicate that the mutL gene plays a significant role in B. amyloliquefaciens YT1’s biofilm development.

Figure 1.
(a,b) Biofilm formation of WT and mutant. (c) Dry weight analysis of biofilms in WT and mutant. a and b represent significant differences in dry weight data between WT and mutant.

Figure 2.
(a,b) Depictions of altered colony architecture in WT and mutant. (c) Evaluation of the reproductive rates between WT and mutant.
3.2. No Significant Difference in the Antibacterial Activity
On Petri dishes inoculated effectively with R. solani, both the WT YT1 and the mutant ΔmutL were able to consistently form normal and relatively fixed antibacterial zones after 24–72 h of confrontation cultivation. The fungal mycelium of the pathogen was unable to cross this antibacterial zone and continue its expansion, exhibiting an upward growth pattern of the mycelium. No significant difference in the size of the antibacterial zones was observed between the two strains (Figure 3).
Figure 3.
(a) Differences in the inhibition of pathogenic fungi between WT and mutant. (b) Measurement of the inhibition zone diameter between WT and mutant. a and a represent no significant differences in antibiotic circle data between WT and mutant.
3.3. Significant Decrease in Colonization Ability of the Mutant ΔmutL
This study utilized GFP-labeling technology to observe the colonization of B. amyloliquefaciens YT1 and mutant ΔmutL on rice straw inoculated with R. solani (Figure 4). Although the number of both strains consistently showed a decreasing trend between the first and twelfth days, there was a significant difference in their performances. On day 8, B. amyloliquefaciens YT1 exhibited a distinct aggregation effect at the site of infection, inhibiting the spread of the pathogenic fungus, whereas the mutant ΔmutL never showed a clear aggregation effect. From the eighth day to the twelfth day, as the number of organisms decreased sharply, the colonization capacity of both strains also decreased.

Figure 4.
The colonization of the rice plant against rice sheath blight between WT and mutant.
3.4. Significant Reduction in the Biocontrol Efficacy of the ΔmutL Mutant against Rice Sheath Blight
After 12 days of effective observation, the B. amyloliquefaciens YT1 strain exhibited peak biocontrol efficacy of 63.2% on the fourth day, after which it progressively decreased to 42.9% by the twelfth day (Table 2). The decline can be ascribed to the initial onset of R. solani spread on the fourth day. In contrast, the mutL mutant strain demonstrated a biocontrol efficiency of 15.8%, significantly inferior to that of the WT B. amyloliquefaciens YT1. As the disease progressed rapidly, the biocontrol efficacies of both the WT B. amyloliquefaciens YT1 and the mutL mutant substantially declined. Nonetheless, at any given time point, the biocontrol effects of the B. amyloliquefaciens YT1 were consistently superior to those of the ΔmutL. Particularly on the twelfth day, the biocontrol efficiency of the ΔmutL was only about 24.9% of the WT B. amyloliquefaciens YT1 (Table 2). These findings indicate that the absence of regulation by the mutL gene led to a significant decrease in the biocontrol efficacy of the MutL mutant over time.

Table 2.
Biocontrol of rice sheath blight in pot cultures of the WT B. amyloliquefaciens YT1 and the ΔmutL. a, b, c represent the differences between the data or whether there is a significant difference, for example, there is a significant difference between a and b or c.
3.5. Comparative Analysis of Differential Gene Expression in B. amyloliquefaciens YT1 and the ΔmutL Mutant
The identification of differentially expressed genes was achieved through the analysis of gene transcription (Table 3). This table lists the key regulatory genes that have been reported in recent years to directly and significantly control the formation of biofilms. In this study, compared to the control YT1, some reported and confirmed signaling pathway regulatory factors in the mutant ΔmutL strain showed significant abnormal expression. For example, there was a notable decrease in the expression of genes senN, capB, and the appA family, as well as abnormal increases in the expression of genes spo0A, sinR, and abrB. The transcriptional expression levels of tasA, a protein involved in biofilm matrix formation, and the eps family proteins, which are also components of the biofilm skeleton, were also found to be decreased, although not significantly.

Table 3.
Comparative analysis of differentially expressed genes in YT1 and the ΔmutL mutant.
4. Discussion
Due to varying environmental conditions, Bacillus exists in multiple forms in nature, including free-living, motile, and dormant cells [7,37]. As an outstanding biocontrol agent, Bacillus is commonly employed to manage fungal diseases in crops such as rice and wheat. B. subtilis E1R-J has been shown to effectively inhibit diseases such as wheat take-all, wheat stripe rust, and wheat powdery mildew [38,39,40]. Additionally, rice sheath blight, a prevalent fungal disease in rice crops that causes over 15% yield loss, can be effectively controlled by B. subtilis MBI 600 [41,42].
Biofilms are highly organized communities of microorganisms composed of amyloid fibers (TasA) and exopolysaccharides (EPS), which adhere to the surfaces of cells [43,44,45]. The formation of the biofilm in Bacillus is controlled by a complex and strictly regulated signaling pathway, which is mainly composed of two groups of proteins: the global regulatory protein Spo0A and the specialized regulatory proteins SinR, SinI, and SlrR. Starting with the mutL gene identified as a biofilm formation defect, this study successfully constructed a directed knockout mutant of the gene and verified the phenotypic characteristics of the mutant’s defect in biofilm formation. The severely reduced colonization capacity and the efficacy of preventing rice blight were likely indirectly caused by the significantly decreased intensity of biofilm formation.
The target gene mutL, as a highly conserved protein, is widely present in bacterial genomes, and its main reported function is an important part of DNA mismatch repair (MMR) [46]. B. amyloliquefaciens YT1, being an effective biocontrol bacterium, has been utilized in rice fields for a long time. Transcriptome data have shown that these different genes reported are all expressed to varying degrees, with one important gene, capB, being significantly downregulated. The main mechanism of action of capB is to regulate the assembly and utilization of glutamate in the process of biofilm formation [47]. The resulting polyglutamic acid γ-PGA is an important filler in the structure of biofilms and is indispensable [48]. In this investigation, the transcription of the gene was markedly reduced. Therefore, our research may achieve global regulation of biofilm formation through the glutamate-γ-PGA signaling pathway.
We ultimately confirmed the significant positive regulatory role of the MutL protein in the biofilm formation process of strain YT1. After multiple confirmations, the experimental results were stable and reliable, which fully demonstrates that the MutL protein plays a key role in the biofilm formation process and even the growth and development process of Bacillus species. This provides a new research area for the study of biofilm mechanisms. Furthermore, subsequent work in this study will aim to reveal the detailed mechanism of MutL’s action, contributing to the study of biofilm regulatory pathways and laying a solid theoretical foundation for the improvement of microbial pesticides by Bacillus species.
Author Contributions
Methodology, H.Z., H.C. and B.L. (Baoyou Liu); Software, H.C.; Validation, H.Z., H.C. and B.L. (Binghui Luan); Formal analysis, H.Z., M.C., B.L. (Binghui Luan) and B.L. (Baoyou Liu); Investigation, H.W. and B.L. (Binghui Luan); Resources, H.Z., B.L. (Baoyan Li), H.W. and B.L. (Baoyou Liu); Data curation, H.Z. and B.L. (Baoyou Liu); Writing—original draft, H.Z. and B.L. (Baoyou Liu); Visualization, H.Z. and S.W.; Supervision, H.W. and S.W.; Project administration, S.W.; Funding acquisition, H.Z. and B.L. (Baoyou Liu). All authors have read and agreed to the published version of the manuscript.
Funding
This research was funded by [Project of Shandong Natural Science Foundation] [ZR2020KC026], [Science and Technology Planning Project of Yantai] [2021NYNC015, 2022XCZX094, 2023ZDCX026], [Shandong Province Fruit Industry Technology System] [SDAIT-06-11], [Shandong Province Key R&D Program] [2021CXGC010602, 2021CXGC010802], [Monitoring and Control Project of Crop Diseases, Pests and Rodents Epidemic in the Ministry of Agriculture and Rural Affairs] [152307026], [Shandong Province Science and Technology Small and Medium Enterprises Innovation Ability Enhancement Project] [2023TSGC0829, 2023TSGC0894] And The APC was funded by [ZR2020KC026].
Institutional Review Board Statement
Not applicable.
Data Availability Statement
Dataset available upon request from the authors.
Acknowledgments
Special thanks to Zhiyi Chen for guidance on this study.
Conflicts of Interest
The authors declare no conflicts of interest.
References
- Haggag, W.M.; Timmusk, S. Colonization of peanut roots by biofilm-forming Paenibacillus polymyxa initiates biocontrol against crown rot disease. J. Appl. Microbiol. 2008, 104, 961–969. [Google Scholar] [CrossRef] [PubMed]
- Stewart, P.S.; Franklin, M.J. Physiological heterogeneity in biofilms. Nat. Rev. Microbiol. 2008, 6, 199–210. [Google Scholar] [CrossRef] [PubMed]
- Vlamakis, H.; Chai, Y.; Beauregard, P.; Losick, R.; Kolter, R. Sticking together: Building a biofilm the Bacillus subtilis way. Nat. Rev. Microbiol. 2013, 11, 157–168. [Google Scholar] [CrossRef] [PubMed]
- Weng, J.; Wang, Y.; Li, J.; Shen, Q.; Zhang, R. Enhanced root colonization and biocontrol activity of Bacillus amyloliquefaciens SQR9 by abrB gene disruption. Appl. Microbiol. Biotechnol. 2013, 97, 8823–8830. [Google Scholar] [CrossRef] [PubMed]
- Goswami, D.; Thakker, J.N.; Dhandhukia, P.C. Portraying mechanics of plant growth promoting rhizobacteria (PGPR): A review. Cogent Food Agric. 2016, 2, 1127500. [Google Scholar] [CrossRef]
- Bais, H.P.; Fall, R.; Vivanco, J.M. Biocontrol of Bacillus subtilis against infection of Arabidopsis roots by Pseudomonas syringae is facilitated by biofilm formation and surfactin production. Plant Physiol. 2004, 134, 307–319. [Google Scholar] [CrossRef] [PubMed]
- Kantiwal, U.; Pandey, J. Efficient Inhibition of Bacterial Biofilm through Interference of Protein–Protein Interaction of Master Regulator Proteins: A Proof of Concept Study with SinR-SinI Complex of Bacillus subtilis. Appl. Biochem. Biotechnol. 2023, 195, 1947–1967. [Google Scholar] [CrossRef] [PubMed]
- Monds, R.D.; O’Toole, G.A. The developmental model of microbial biofilms: Ten years of a paradigm up for review. Trends Microbiol. 2009, 17, 73–87. [Google Scholar] [CrossRef] [PubMed]
- Wang, D.; Zeng, N.; Li, C.; Li, Z.; Zhang, N.; Li, B. Fungal biofilm formation and its regulatory mechanism. Heliyon 2024, 10, e32766. [Google Scholar] [CrossRef] [PubMed]
- Gu, Y.; Liu, Y.; Mao, W.; Peng, Y.; Han, X.; Jin, H.; Xu, J.; Chang, L.; Hou, Y.; Shen, X. Functional versatility of Zur in metal homeostasis, motility, biofilm formation, and stress resistance in Yersinia pseudotuberculosis. Microbiol. Spectr. 2024, 12, e3723–e3756. [Google Scholar] [CrossRef]
- Zegadło, K.; Gieroń, M.; Żarnowiec, P.; Durlik-Popińska, K.; Kręcisz, B.; Kaca, W.; Czerwonka, G. Bacterial motility and its role in skin and wound infections. Int. J. Mol. Sci. 2023, 24, 1707. [Google Scholar] [CrossRef] [PubMed]
- Arnaouteli, S.; Bamford, N.C.; Stanley-Wall, N.R.; Kovács, Á.T. Bacillus subtilis biofilm formation and social interactions. Nat. Rev. Microbiol. 2021, 19, 600–614. [Google Scholar] [CrossRef] [PubMed]
- Flemming, H.; van Hullebusch, E.D.; Neu, T.R.; Nielsen, P.H.; Seviour, T.; Stoodley, P.; Wingender, J.; Wuertz, S. The biofilm matrix: Multitasking in a shared space. Nat. Rev. Microbiol. 2023, 21, 70–86. [Google Scholar] [CrossRef] [PubMed]
- Flemming, H.; Wingender, J. The biofilm matrix. Nat. Rev. Microbiol. 2010, 8, 623–633. [Google Scholar] [CrossRef] [PubMed]
- Branda, S.S.; González-Pastor, J.E.; Ben-Yehuda, S.; Losick, R.; Kolter, R. Fruiting body formation by Bacillus subtilis. Proc. Natl. Acad. Sci. USA 2001, 98, 11621–11626. [Google Scholar] [CrossRef] [PubMed]
- Gallegos-Monterrosa, R.; Kankel, S.; Götze, S.; Barnett, R.; Stallforth, P.; Kovács, Á.T. Lysinibacillus fusiformis M5 induces increased complexity in Bacillus subtilis 168 colony biofilms via hypoxanthine. J. Bacteriol. 2017, 199, 10–1128. [Google Scholar] [CrossRef] [PubMed]
- Cámara-Almirón, J.; Navarro, Y.; Magno-Pérez-Bryan, M.C.; Molina-Santiago, C.; Pearson, J.R.; Díaz-Martínez, L.; de Vicente, A.; Pérez-García, A.; Romero, D. Dual functionality of the TasA amyloid protein in Bacillus physiology and fitness on the phylloplane. Nat. Commun. 2020, 11, 1859. [Google Scholar] [CrossRef] [PubMed]
- Chen, R.; Liu, N.; Ren, Y.; Cui, T. Transcriptomic and biochemical analysis of metabolic remodeling in Bacillus subtilis MSC4 under Benzo [a] pyrene stress. Chemosphere 2024, 353, 141637. [Google Scholar] [CrossRef] [PubMed]
- Whitchurch, C.B.; Tolker-Nielsen, T.; Ragas, P.C.; Mattick, J.S. Extracellular DNA required for bacterial biofilm formation. Science 2002, 295, 1487. [Google Scholar] [CrossRef] [PubMed]
- Yu, Y.; Yan, F.; Chen, Y.; Jin, C.; Guo, J.; Chai, Y. Poly-γ-glutamic acids contribute to biofilm formation and plant root colonization in selected environmental isolates of Bacillus subtilis. Front. Microbiol. 2016, 7, 1811. [Google Scholar] [CrossRef] [PubMed]
- Oppenheimer-Shaanan, Y.; Sibony-Nevo, O.; Bloom-Ackermann, Z.; Suissa, R.; Steinberg, N.; Kartvelishvily, E.; Brumfeld, V.; Kolodkin-Gal, I. Spatio-temporal assembly of functional mineral scaffolds within microbial biofilms. Npj Biofilms Microbiomes 2016, 2, 15031. [Google Scholar] [CrossRef] [PubMed]
- López, D.; Kolter, R. Extracellular signals that define distinct and coexisting cell fates in Bacillus subtilis. FEMS Microbiol. Rev. 2010, 34, 134–149. [Google Scholar] [CrossRef] [PubMed]
- Bakalakos, M.; Ampadiotaki, M.; Vlachos, C.; Sipsas, N.; Pneumaticos, S.; Vlamis, J. Molecular Mechanisms of Biofilm Formation on Orthopaedic Implants: Review of the Literature. Maedica 2024, 19, 129. [Google Scholar] [CrossRef] [PubMed]
- Kovács, A.T.; Gallegos-Monterrosa, R. Phenotypic plasticity: The role of a phosphatase family in the genetic regulation of Bacillus. Mol. Microbiol. 2023, 120, 20–31. [Google Scholar]
- Guttenplan, S.B.; Blair, K.M.; Kearns, D.B. The EpsE flagellar clutch is bifunctional and synergizes with EPS biosynthesis to promote Bacillus subtilis biofilm formation. PLoS Genet. 2010, 6, e1001243. [Google Scholar] [CrossRef] [PubMed]
- Sharipova, M.R.; Mardanova, A.M.; Rudakova, N.L.; Pudova, D.S. Bistability and formation of the biofilm matrix as adaptive mechanisms during the stationary phase of Bacillus subtilis. Microbiology 2021, 90, 20–36. [Google Scholar] [CrossRef]
- Blair, K.M.; Turner, L.; Winkelman, J.T.; Berg, H.C.; Kearns, D.B. A molecular clutch disables flagella in the Bacillus subtilis biofilm. Science 2008, 320, 1636–1638. [Google Scholar] [CrossRef] [PubMed]
- Liang, Z.; Qiao, J.; Li, P.; Zhang, L.; Qiao, Z.; Lin, L.; Yu, C.; Yang, Y.; Zubair, M.; Gu, Q. A novel Rap-Phr system in Bacillus velezensis NAU-B3 regulates surfactin production and sporulation via interaction with ComA. Appl. Microbiol. Biotechnol. 2020, 104, 10059–10074. [Google Scholar] [CrossRef] [PubMed]
- Marlow, V.L.; Porter, M.; Hobley, L.; Kiley, T.B.; Swedlow, J.R.; Davidson, F.A.; Stanley-Wall, N.R. Phosphorylated DegU manipulates cell fate differentiation in the Bacillus subtilis biofilm. J. Bacteriol. 2014, 196, 16–27. [Google Scholar] [CrossRef]
- Hobley, L.; Ostrowski, A.; Rao, F.V.; Bromley, K.M.; Porter, M.; Prescott, A.R.; MacPhee, C.E.; Van Aalten, D.M.; Stanley-Wall, N.R. BslA is a self-assembling bacterial hydrophobin that coats the Bacillus subtilis biofilm. Proc. Natl. Acad. Sci. USA 2013, 110, 13600–13605. [Google Scholar] [CrossRef] [PubMed]
- Da Silva Filho, R.G.; Campos, A.C.; Souza, I.D.S.; Saramago, C.S.D.M.; de Lima E Silva, A.A. Production of Poly-γ-Glutamic Acid (γ-PGA) by Clinical Isolates of. Open Microbiol. J. 2020, 14, 30–37. [Google Scholar] [CrossRef]
- Chen, J.; Wang, C.; Shu, C.; Zhu, M.; Zhou, E. Isolation and characterization of a melanin from Rhizoctonia solani, the causal agent of rice sheath blight. Eur. J. Plant Pathol. 2015, 142, 281–290. [Google Scholar] [CrossRef]
- Liu, S.; Huang, J.; Zhang, C.; Wang, L.; Fan, C.; Zhong, C. Probing the growth and mechanical properties of Bacillus subtilis biofilms through genetic mutation strategies. Synth. Syst. Biotechnol. 2022, 7, 965–971. [Google Scholar] [CrossRef] [PubMed]
- Tran, P.; Lander, S.M.; Prindle, A. Active pH regulation facilitates Bacillus subtilis biofilm development in a minimally buffered environment. Mbio 2024, 15, e3323–e3387. [Google Scholar] [CrossRef] [PubMed]
- Luo, C.; Zhou, H.; Zou, J.; Wang, X.; Zhang, R.; Xiang, Y.; Chen, Z. Bacillomycin L and surfactin contribute synergistically to the phenotypic features of Bacillus subtilis 916 and the biocontrol of rice sheath blight induced by Rhizoctonia solani. Appl. Microbiol. Biotechnol. 2015, 99, 1897–1910. [Google Scholar] [CrossRef] [PubMed]
- Zhou, H.F.; Luo, C.P.; Wang, X.Y. Construction of Bacillus subtilis Bs916 mutant libraries by transposon tagging and cloning the genes to the organism’s anti-bacterial activities. Sci. Agric. Sin. 2013, 46, 2232–2239. [Google Scholar]
- Steinberg, N.; Rosenberg, G.; Keren-Paz, A.; Kolodkin-Gal, I. Collective vortex-like movement of Bacillus subtilis facilitates the generation of floating biofilms. Front. Microbiol. 2018, 9, 590. [Google Scholar] [CrossRef] [PubMed]
- Liu, B.; Qiao, H.; Huang, L.; Buchenauer, H.; Han, Q.; Kang, Z.; Gong, Y. Biological control of take-all in wheat by endophytic Bacillus subtilis E1R-j and potential mode of action. Biol. Control 2009, 49, 277–285. [Google Scholar] [CrossRef]
- Li, H.; Zhao, J.; Feng, H.; Huang, L.; Kang, Z. Biological control of wheat stripe rust by an endophytic Bacillus subtilis strain E1R-j in greenhouse and field trials. Crop Prot. 2013, 43, 201–206. [Google Scholar] [CrossRef]
- Gao, X.; Gong, Y.; Huo, Y.; Han, Q.; Kang, Z.; Huang, L. Endophytic Bacillus subtilis strain E1R-J is a promising biocontrol agent for wheat powdery mildew. Biomed. Res. Int. 2015, 2015, 462645. [Google Scholar] [CrossRef] [PubMed]
- Kumar, K.V.K.; Yellareddygari, S.K.; Reddy, M.S.; Kloepper, J.W.; Lawrence, K.S.; Zhou, X.G.; Sudini, H.; Groth, D.E.; Raju, S.K.; Miller, M.E. Efficacy of Bacillus subtilis MBI 600 against sheath blight caused by Rhizoctonia solani and on growth and yield of rice. Rice Sci. 2012, 19, 55–63. [Google Scholar] [CrossRef]
- Krishna Kumar, K.V.; Yellareddygari, S.K.; Reddy, M.S.; Kloepper, J.W.; Lawrence, K.S.; Miller, M.E.; Sudini, H.; Surendranatha Reddy, E.S.; Zhou, X.G.; Groth, D.E. Ultrastructural studies on the interaction between Bacillus subtilis MBI 600 (Integral®) and the rice sheath blight pathogen, Rhizoctonia solani. Afr. J. Microbiol. Res. 2013, 7, 2078–2086. [Google Scholar]
- Branda, S.S.; Chu, F.; Kearns, D.B.; Losick, R.; Kolter, R. A major protein component of the Bacillus subtilis biofilm matrix. Mol. Microbiol. 2006, 59, 1229–1238. [Google Scholar] [CrossRef] [PubMed]
- López, D.; Vlamakis, H.; Kolter, R. Biofilms. Csh Perspect. Biol. 2010, 2, a398. [Google Scholar] [CrossRef] [PubMed]
- Romero, D.; Vlamakis, H.; Losick, R.; Kolter, R. An accessory protein required for anchoring and assembly of amyloid fibres in B. subtilis biofilms. Mol. Microbiol. 2011, 80, 1155–1168. [Google Scholar] [CrossRef] [PubMed]
- Guarné, A. The functions of MutL in mismatch repair: The power of multitasking. Prog. Mol. Biol. Transl. 2012, 110, 41–70. [Google Scholar]
- Liu, J.; He, D.; Li, X.; Gao, S.; Wu, H.; Liu, W.; Gao, X.; Zhou, T. γ-Polyglutamic acid (γ-PGA) produced by Bacillus amyloliquefaciens C06 promoting its colonization on fruit surface. Int. J. Food Microbiol. 2010, 142, 190–197. [Google Scholar] [CrossRef]
- Liu, J.; Hanne, J.; Britton, B.M.; Bennett, J.; Kim, D.; Lee, J.; Fishel, R. Cascading MutS and MutL sliding clamps control DNA diffusion to activate mismatch repair. Nature 2016, 539, 583–587. [Google Scholar] [CrossRef] [PubMed]
Disclaimer/Publisher’s Note: The statements, opinions and data contained in all publications are solely those of the individual author(s) and contributor(s) and not of MDPI and/or the editor(s). MDPI and/or the editor(s) disclaim responsibility for any injury to people or property resulting from any ideas, methods, instructions or products referred to in the content. |
© 2024 by the authors. Licensee MDPI, Basel, Switzerland. This article is an open access article distributed under the terms and conditions of the Creative Commons Attribution (CC BY) license (https://creativecommons.org/licenses/by/4.0/).